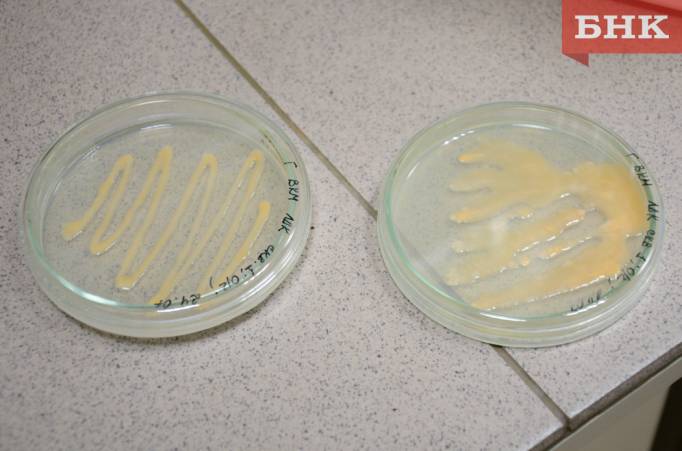

Удобрения, биопрепараты, сорбенты и ферменты: как биотехнологи в Коми превращают отходы в доходы
БНК 25.11.2025
Несколько десятилетий специалисты Коми научного центра изучают, как живые организмы могут помочь человечеству и что сделать из все больше появляющихся отходов производств. Старший научный сотрудник Института биологии КНЦ Татьяна Щемелинина рассказала корреспонденту БНК про самые перспективные разработки и чем биотехнологи занимаются сейчас.
В рабочей коллекции института биологии поддерживаются около 80 штаммов микроорганизмов, выделенных из загрязненных почв и сточных вод. Так как они способны жить в такой среде, то могут и перерабатывать загрязнители.
— Знаете, у нас такая профдеформация: куда бы мы не ехали, всегда привозим образцы почв, грунта и воды для выделения из них штаммов, — поделилась ученый.
Сохранение в коллекции микроорганизмов требует особых условий: стерильности, определенных температур, периодических пересевов. Коллекционные штаммы могут пригодиться в будущем: если вдруг понадобится очистить какую-то территорию, у ученых уже будет нужный образец штамма. Но выделение и сохранение штаммов – это только начало научной работы: для создания продукта нужны еще лабораторные и опытно-промышленные эксперименты, оценка его токсичности и регистрация.
Среди уже разработанных продуктов Татьяна Щемелинина показала биогеосорбент, появившийся в 2016 году. Он очищает от органических загрязнителей, в основном нефти и нефтепродуктов. В основе препарата — микроорганизмы, которые иммобилизованы на глауконитовом минерале, выполняющим три функции: «базы-транспорта», сорбента и питания для микроорганизмов.
Сорбент впитывает загрязнители, а микроорганизмы разлагают их. Препарат либо вносят вручную на загрязненную почву, либо разбрызгивают при помощи мотопомп. Вместе с сорбентом нередко вносят семена трав-рекультивантов. Слабые загрязнения удается устранить за один сезон.
Другой препарат — биодобавка на основе кофейной шелухи в виде гранул. Шелуха не токсична и содержит в себе комплекс агрохимических элементов. Это и подтолкнуло биотехнологов к созданию биоудобрения, которое стимулирует рост растений. Оно состоит не только из отходов кофейного производства, но и добавленных компонентов – микроводорослей и глауконитовой глины. От идеи до патентования разработки прошло два года: исследования длились с 2021-го по 2022 годы.
В удобрение можно превратить и бумажный шлам, отход целлюлозо-бумажных производств. Так, в результате исследований 2023 — 2024 годов ученые получили аналоги азофоски и суперфосфата.
Также в 2019 году администрация Сыктывкара попросила биологов Коми научного центра исследовать склад кородревесных отходов в Лесозаводе. Они складировались туда еще в советское время. Высота свалки в некоторых местах составляет до 27 метров.
Были проведены исследования проб кородревесных отходов, отобранных на разной глубине с разной степенью разложенностью. Анализы показали, что кородревесные отходы могут быть сырьем для получения биотехнологических продуктов, например, удобрений или сорбентов.
С 2024 года в рамках государственного задания биотехнологи исследуют способы и методы получения ферментов с применением лигноцеллюлозных отходов. Вещества используются, например, в качестве отбеливающих веществ в стиральных порошках, в производстве сыра, хлеба и вина, для улучшение пищеварения у коров, стимуляции роста растений, защиты их от болезней.
Сейчас ученые сконцентрированы на получении целлюлазы для отбелки. Эта тема весьма актуальна в рамках задач биоэкономики и импортозамещения страны. В России есть лишь две компании по производству ферментов, обеспечение которыми страны составляет всего 16%. Продуцентами ферментов являются грибы-трутовики, растущие на деревьях и пнях и питающиеся целлюлозой и лигнином.
— Разрабатывая технологии получение каких-либо биопродуктов, мы стараемся следовать задачам циркулярной экономики, то есть все отходы превращаем в доходы, — резюмировала Татьяна Щемелинина.
Алексей Баталов


Удобрения, биопрепараты, сорбенты и ферменты: как биотехнологи в Коми превращают отходы в доходы